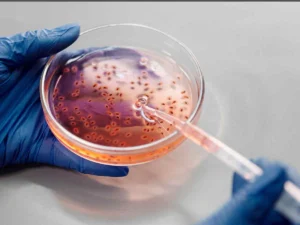
Bacteriën doden

Waarom desinfecteren in de voedingsindustrie een noodzaak is
Desinfecteren in de voedingsindustrie. Is dat nodig? Korte antwoord is: JA! Dit is om de volksgezondheid te beschermen. Goede en slechte micro-organismen In de voedingsindustrie komen micro-organismen voor.